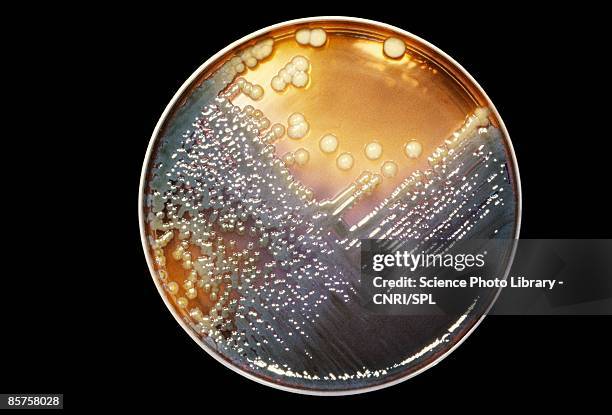

Enterobacter bacteria - stock photo

Get this image in a variety of framing options at Photos.com.
PURCHASE A LICENSE
All Royalty-Free licenses include global use rights, comprehensive protection, simple pricing with volume discounts available
€300.00
EUR
Getty ImagesEnterobacter Bacteria High-Res Stock Photo
Download premium, authentic Enterobacter bacteria stock photos from 51³Ô¹ÏÍø Explore similar high-resolution stock photos in our expansive visual catalogue.Product #:85758028
€300€40
Getty Images
In stockDETAILS
51³Ô¹ÏÍø #:
85758028
License type:
Collection:
Brand X Pictures
Max file size:
5111 x 3468 px (17.04 x 11.56 in) - 300 dpi - 5 MB
Upload date:
Release info:
No release required
Categories: